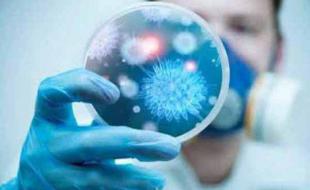
تفاوت‌های کرونا با سرماخوردگی و آنفلوانزا

به گزارشامروله، حسین بیگلری در گفتگو باشبکه اطلاع رسانی مرصاداظهار داشت: هرنوع تب و گلودردی الزاماً به معنای ابتلاء بهکروناویروس نیست زیرا معمولاً هر ساله در اواخر زمستان همآنفلوانزایفصلی و هم سرماخوردگی شایع میشود و وجه افتراق اینها مهم است.
وی با بیان اینکه نقش عوامل زمینهای در بروز آنفلوانزا وکروناویروس حائز اهمیت است، افزود: هر انسانی میتواند در معرض ویروسهای متعددی باشد که سبب سرماخوردگی شود.
رئیس دبیرخانه کارگروه سلامت و امنیت غذایی دانشگاه علوم پزشکی کرمانشاه گفت: انسان جوان بالغ و فردی با سیستم ایمنی قوی هم ممکن است دچار سرماخوردگی شود همچنین در آنفلوانزا علائم همراه با درد شدید عضلانی آغاز میشود و این مشخصه بارزتری است در حالی که درکروناویروس و سرماخوردگی این علائم تدریجی است.
این مسئول گفت: این روزها اضطراب در میان عدهای بالا است که سبب میشود عملکرد سیستم ایمنی مختل شود در حالی که برای مراقبت از عفونتهای تنفسی رعایت بهداشت فردی و عمومی نظیر شستشوی مکرر دستها با آب و صابون، خودداری از دست دادن و روبوسی و پرهیز از حضور در مکانهای عمومی توصیه میشود البته این توصیهها برای پیشگیری از ابتلاء به همه بیماریهای تنفسی مؤثر است.
بیگلری تصریح کرد: امسال تاکید شده در اماکن عمومی و شلوغ هم حضور نیابیم و افراد با علائم تب و سرفه در منزل بمانند و استراحت کنند.
وی بیان داشت: در سرماخوردگی عطسه و آبریزش بینی شایع است در حالی که این در آنفلوانزا وکروناکمتر دیده میشود و درکرونادو علامت سرفه خشک و احساس ناراحتی در قفسه سینه دیده میشود اما فردی که دچار اضطراب زیاد شود، این علائم به دنبال تلقین در وی دیده خواهد شد.
رئیس دبیرخانه کارگروه سلامت و امنیت غذایی دانشگاه علوم پزشکی کرمانشاه ادامه داد: باید موضوع را ازنظر رعایت بهداشت جهت پیشگیری از ابتلاء به عفونتهای تنفسی جدی بگیریم و دچار اضطراب نشویم زیرا بسیاری از افراد به دنبال اضطراب اقدام به استفاده ازوایتکسو جوهر نمک میکنند که با ترکیب این دو علائم سرفه و تنگی تنفس که همان علائمکروناویروس است، ایجاد خواهد شد، در حالی که این یک واکنش شیمیایی است.
این مسئول افزود: درسالهایقبل هم در آستانه نوروز هشدار داده میشد زنان خانه دار این را به عنوان یک مخاطره برای دستگاه تنفسی، چشم، دستها و پوست در هنگام خانه تکانی در نظر بگیرند ترکیب این دو باید به صورت رقیق شده و با تهویه مناسب انجام شود در غیر این صورت سببمتساعدشدن گازهایی خواهد شد که به مجاری تنفسی آسیب میزند.
بیگلری عنوان کرد: به دلیل انتشار عفونتهای تنفسی عدهای از ماسک و دستکش به مدت طولانی استفاده میکنند که اگر خیس یا آلوده باشند و در محیط رها شوند خطر انتشار عفونتهای تنفسی را افزایش میدهند زیرا هم در آنفلوانزا و هم درکرونا، ویروس میتواند مدتی در محیط زنده بماند بنابراین اولاً نیازی به استفاده همگان از ماسک و دستکش نیست و در صورت استفاده هم باید ضمن قرار دادن در نایلونهای ویژه به سطل زباله انداخته و از پرتاب آن خودداری شود زیرا به عنوان یک مخزن انتشار آلودگی میتواند عمل کند.